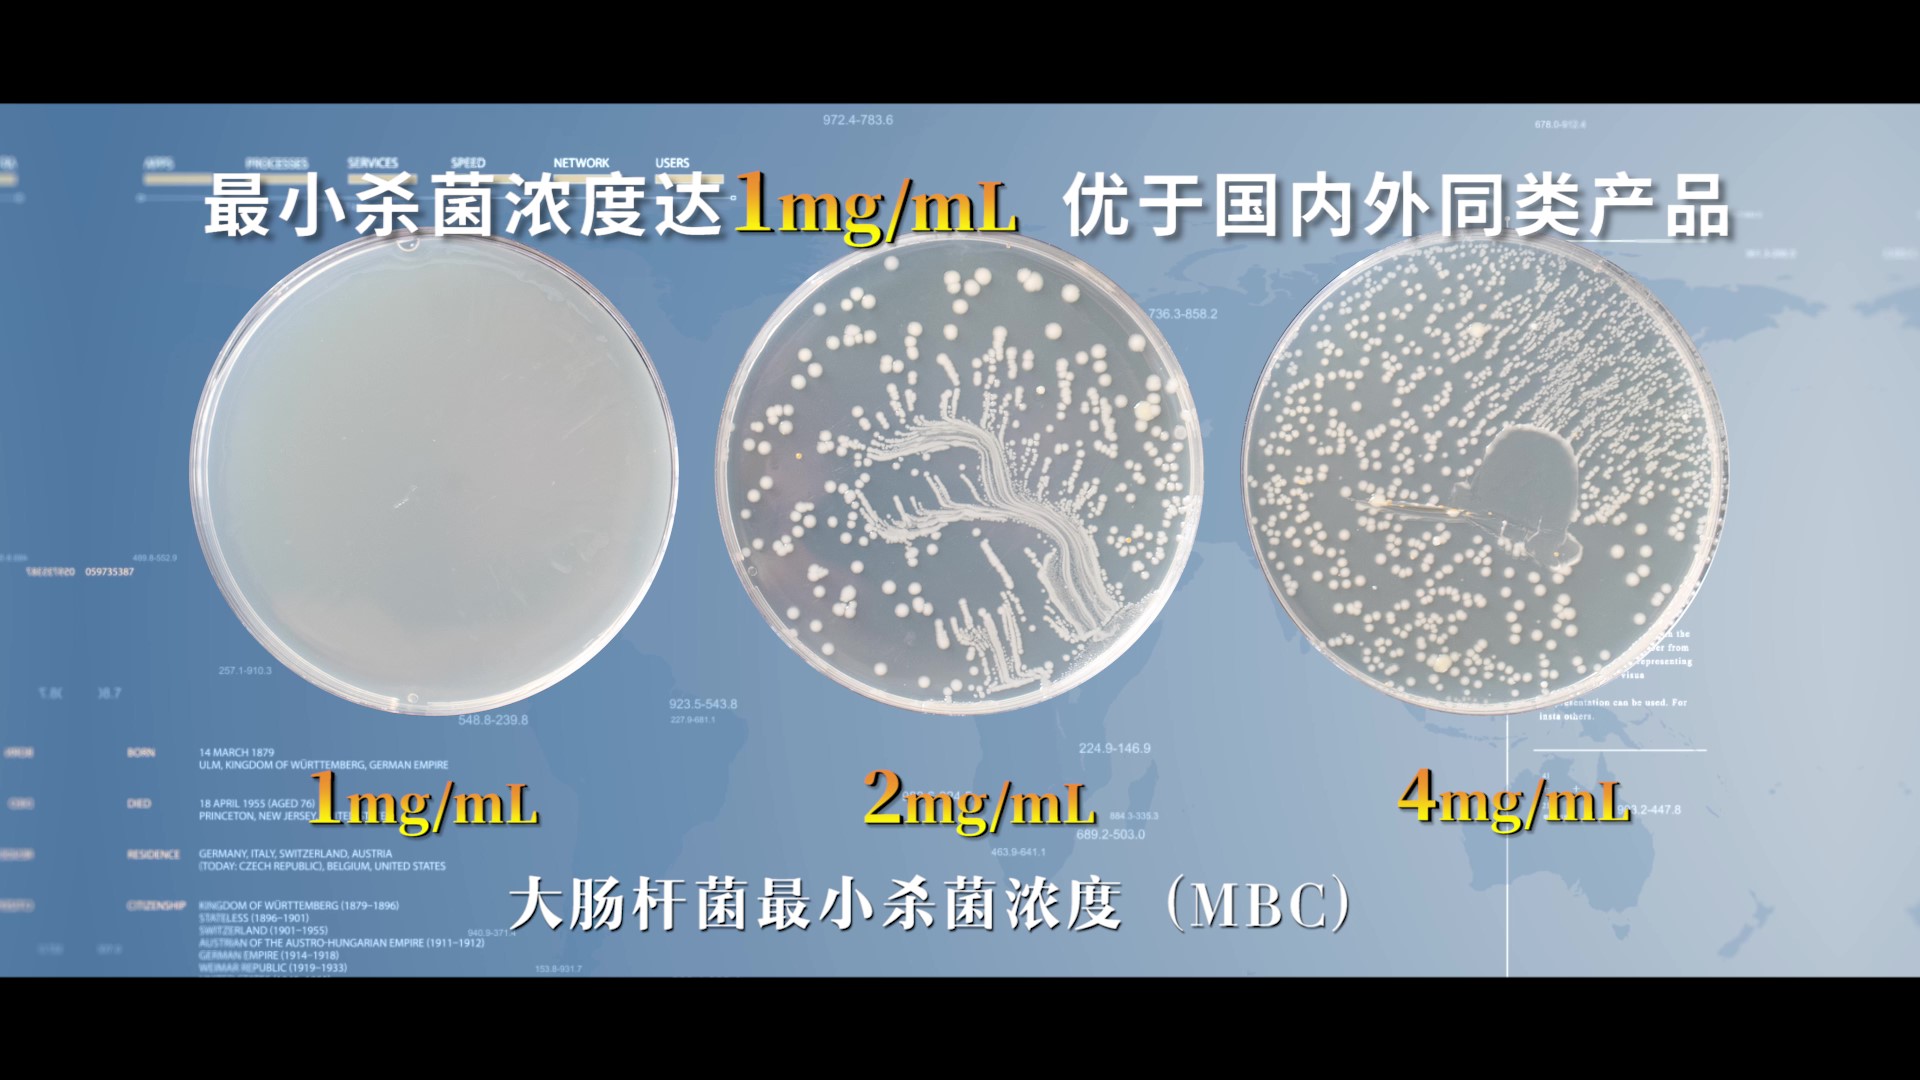

商铺名称:浙江华特新材料有限公司
联系人:胡秉坚(先生)
联系手机:
固定电话:
企业邮箱:1078013971@qq.com
联系地址:浙江省湖州市安吉县递铺街道浦汇路198号
邮编:313300
联系我时,请说是在汽配名企网上看到的,谢谢!
商品详情
| 产品参数 | |||
|---|---|---|---|
| 有效成分含量 | 99% | ||
| 是否进口 | 否 | ||
| 用途范围 | 抗菌防霉剂 | ||
| 外观 | 米白色粉末 | ||
| 特色服务 | 技术支持 | ||
| 是否危险化学品 | 否 | ||
| 成分 | 有机改性金属离子硅酸盐 | ||
| 含湿量 | ≤5% | ||
| 目数 | 200目 | ||
| 灼烧失量 | ≤40% | ||
| 产地 | 浙江安吉 | ||
| 工艺等级 | 工业级 | ||
| 储存方式 | 干燥恒温 | ||
| 是否含有生物毒性 | 否 | ||
| 应用范围 | 建筑涂料,船舶涂料、金属漆、地板等 | ||
| 包装 | 25kg/包 | ||
| 品牌 | 华特/丰虹 | ||

.jpg)